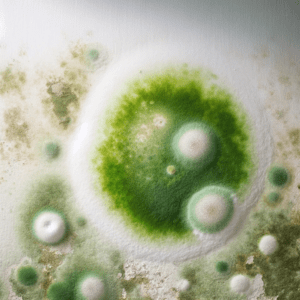
Grüner Schimmel auf Wand
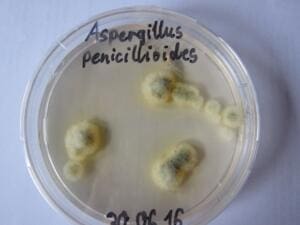

Schimmelbekämpfung – Schimmel im Haus: Alles, was Sie über die unterschiedlichen Schimmelpilze, Gefahren, Ursachen und Lösungen wissen müssen.
Die Schimmelbekämpfung in Haus oder Wohnung ist eine ernsthafte Angelegenheit, die Hauseigentümer, Vermieter und Mieter nicht unterschätzen sollten. Einmal ausgebreitet, erfordert das Entfernen von Schimmel oft viel Arbeit und hohe Kosten. Doch wie entsteht Schimmel, welche Ursachen gibt es und helfen Luftreiniger? Durch richtige Vorbeugung, wie etwa richtiges Lüften, lässt sich Schimmelbildung verhindern und damit viel Ärger ersparen. Erfahren Sie die wichtigsten Fragen und Antworten zu Schimmel, seinen Ursachen, Gesundheitsrisiken und effektiven Gegenmaßnahmen.
Wo entsteht Schimmel im Haus oder der Wohnung?
Ein Schimmelbefall im Haus oder der Wohnung kann unterschiedlichste Gründe haben. Auch darum ist es essentiell wichtig, es erst gar nicht zu einem Befall kommen zu lassen.
Zu den häufigsten Ursachen von Schimmelpilzen gehört Feuchtigkeit – beispielsweise in Gemäuern, dem Keller, der Küche oder dem Badezimmer. So kann beispielsweise durch einen Defekt in einer Wasserleitung über einen längeren Zeitraum Wasser ins Gemäuer sickern, ohne dass es die Bewohner selbst feststellen. Auch in Küchen und Badezimmern, in denen die Raumluft nur wenig oder gar nicht zirkuliert, ist die Gefahr eines Schimmelbefalls erhöht.
Wie entsteht Schimmel im Haus?
Wird das Badezimmer oder die Küche beispielsweise nicht regelmäßig gelüftet, oder verfügt weder über eine Lüftungsanlage, Luftentfeuchter oder Fenster, ist zusätzliche Vorsicht angebracht. Denn nach dem Duschen oder dem Kochen bleibt die Luftfeuchtigkeit sonst über längere Zeit in der Raumluft. Dies bietet dem Schimmel die beste Grundlage sich anzusiedeln und zu wachsen – auch die Konzentration von Schimmelpilzsporen nimmt so stetig zu. Von dort aus verbreitet sich der Pilz dann über die Luft in weitere Räume des Hauses oder der Wohnung.
Darüber hinaus können auch äußere Einflüsse Schimmelbefall begünstigen. Gerade in ufernahen Gegenden, in denen regelmäßig Hochwasser zu erwarten sind, kann sich Feuchtigkeit langfristig in den Gemäuern von Kellerräumen und unteren Etagen von Gebäuden festsetzen.
Hier droht die Gefahr eines Schimmelbefalls gerade in öffentlichen Gebäuden, da diese oft älteren Baujahres sind und nicht in der notwenigen Regelmäßigkeit auf mögliche Wasserschäden hin kontrolliert wird oder kontrolliert werden kann, da ein Schimmelbefall oft erst sichtbar wird, wenn es bereits zu spät ist.
Sind die Sporen einmal im feuchten Gemäuer, breiten sich diese durch die Raumluft im gesamten Gebäude aus und gefährden die Gesundheit der Bewohner.
Welche Schimmelarten befallen Gebäude am häufigsten?
Es gibt unterschiedliche Schimmelpilzarten, die häufig in Gebäuden vorkommen. Diese sondern Pilzgifte ab, die für den Menschen gesundheitsschädlich sein können, wenn die Konzentration entsprechend hoch ist.
Das sind die die häufigsten Schimmelpilzarten in Häusern und Wohnungen – Ursachen, Aussehen und Gesundheitsrisiken im Überblick:
Schwarzer Schimmel
Schwarzschimmel gilt als der gefürchtetste und bekannteste Schimmelpilz in Wohnräumen. Schwarzer Schimmel tritt insbesondere bei Feuchtigkeitsproblemen in oder an Wänden häufig auf. Mauern, Tapeten, verputzte Wände und Decken und auch Fliesenfugen sind besonders gefährdet. Große Temperaturunterschiede sind für den Schwarzschimmel kein Problem – er wächst bei einer Temperaturspanne von ca. 6°C bis ca. 45°C.

Schwarzer Schimmel an der Wand mit Feuchtigkeitsmessgerät an der Wand
Schwarzer Schimmel kann Krankheiten von Allergien über Nierenerkrankungen bis hin zu schweren Infektionskrankheiten verursachen.
Grüner Schimmel
Der verbreitetste Schimmel ist „Aspergillus fumigatus“. Dieser Pilz lässt sich sehr häufig auf Lebensmitteln und Blumenerde finden. Doch auch auf feuchten Wänden und Decken in Gebäuden ist diese Pilzsorte zu finden. Auch dieser Schimmelpilz kann sich seine Sporen in der ganzen Wohnung ausbreiten.
Grüner Schimmel auf der Wand ist nicht nur unschön, sondern kann auch gesundheitliche Folgen haben.
Sein Pilzgift Gliotoxin ist zwar nicht extrem schädlich für Tiere oder Menschen, wirkt sich allerdings negativ auf das Immunsystem aus, kann dieses schwächen.
Weißer Schimmel
Weißer Schimmel bleibt oftmals lange unerkannt. Dies ist darauf zurückzuführen, dass diese Pilzart auf hellen Untergründen wie Putz oder hellen Wandfarben schlecht erkennbar ist. Erst nach einer Weile verfärbt sich weißer Schimmel und wird dunkler und wird somit auch für Bewohner eines Gebäudes optisch sichtbar.

Der Schimmel ist einer einer Ecke von Wand zu Decke.
Weißer Schimmel kann die Schleimhäute reizen. Dies kann zu Nasennebenhöhlenentzündungen, häufigen Erkältungen, Hautkrankheiten, Halskratzen, Husten, chronischer Bronchitis oder Gelenkschmerzen bei den Bewohnern des Gebäudes führen.
Gelber Schimmel
Der gelbe Schimmel „Aspergillus flavus“ wird aufgrund seines weniger auffälligen Erscheinungsbildes in der Wohnung nicht so stark wahrgenommen wie grüner oder schwarzer Schimmel, kann sich jedoch auch in Wohnräumen ansiedeln. Er bevorzugt feuchte Ecken, Baumwollstoffe und Polstermöbel.
Gelber Schimmel von einer Wand in Petrischale
Gelber Schimmel gibt bei seinem Stoffwechsel das Pilzgift Aflatoxin an seine Umwelt ab und ist wie der schwarze Schimmel besonders gesundheitsgefährdend.
Roter Schimmel
Der rote Schimmel „Neurospora“ bzw. „Chrysonilia sitophila“ benötigt zum Wachsen große Mengen Zellulose und wird auch als roter Brotschimmel oder Bäckerschimmel bezeichnet. Er findet sich vor allem auf Getreide, in Mehl und in Backstuben. In Wohnungen stellt insbesondere Papiertapete eine ideale Nahrungsgrundlage für den Schimmelpilz dar.

Roter Schimmel – Handlungsbedarf für das Raumklima.
Der rote Schimmel tritt häufiger in Bad, WC und Küche auf, da die Nährbodenvoraussetzungen dort besser sind als in anderen Wohnräumen. Roter Schimmel kann zu Erkrankungen führen, die in der Lunge auftreten.
Wie lässt sich ein Schimmelbefall vorbeugen?
Um einen Befall durch Schimmel frühzeitig und bestmöglich vorzubeugen, eignen sich bereits einfache Tipps. Die einfachste Möglichkeit Schimmelbefall vorzubeugen ist richtiges Lüften. Doch auch beim Lüften gibt es einige Dinge zu beachten. So sollten Sie im Sommer anders als im Winter lüften und keinesfalls einfach den ganzen Tag das Fenster auf Kippstellung lassen – richtig lüften einfach erklärt.
Schimmelbekämpfung durch Luftreiniger und Luftentfeuchter
Luftreiniger können in solchen Risikogebieten eine nachhaltige Unterstützung sein, da mögliche Schimmelsporen durch die Geräte aus der Luft gefiltert werden. Das bewahrt die Bewohner vor gesundheitlichen Schäden und wirkt einer Ausbreitung der Schimmelsporen entgegen. Sind Gemäuer einmal feucht, ist es nur schwierig diese wieder zu trocknen. Im Inneren von Mauern und Wänden trocknet Feuchtigkeit nur sehr langsam aus, sodass ein Schimmelschaden häufig die Folge ist.
Um sicherzustellen, dass die Gemäuer von Gebäuden keine Feuchtigkeit gespeichert haben, eignet sich eine entsprechende Messung. So lassen sich mögliche Schäden frühzeitig aufdecken. Ist Feuchtigkeit in Mauern und Wänden vorhanden, können Luftentfeuchter erste Abhilfe schaffen. Geeignete Geräte befinden sich neben leistungsstarken Luftreinigern in unserem Angebot.
Wie entfernt man Schimmel? Schimmelbekämpfung mit Schimmelentferner
Um Schimmel zu entfernen eignen sich unterschiedliche Mittel. Man sollte hier allerdings darauf achten, dass man humanverträgliche Schimmelentferner einsetzt. Diese Mittel sind für Menschen – beispielsweise für Familien mit Kindern – nicht gesundheitsschädlich, bekämpfen allerdings die Schimmelpilzsporen in der Luft. Dadurch wird eine weitere Ausbreitung des Pilzes verhindert.
Entdecken Sie unseren umfassenden Ratgeber zur Schimmelbekämpfung
In unserem detaillierten Ratgeber finden Sie eine Vielzahl von Informationen und praktischen Tipps zur effektiven Bekämpfung von Schimmel. Unsere Experten haben umfangreiche Artikel zu verschiedenen Schimmelthemen verfasst, darunter:
- Schimmel entfernen: Erfahren Sie die besten Methoden, um Schimmel sicher und effektiv zu entfernen.
- Schimmel in der Wohnung: Entdecken Sie, wie Sie Schimmel in Ihrer Wohnung erkennen und vorbeugen können.
- Schimmel im Bad: Hier bieten wir spezifische Lösungen für die häufigen Schimmelprobleme in Feuchträumen.
- Schimmel im Keller: Lernen Sie, wie Sie in diesem oft problematischen Bereich Schimmel effektiv bekämpfen.
Jeder Artikel bietet fundierte Ratschläge und Schritt-für-Schritt-Anleitungen, um Ihr Zuhause schimmelfrei zu halten. Lesen Sie mehr im Ratgeber und starten Sie Ihren Weg zu einem gesünderen und schimmelfreien Zuhause.
Schimmelbefall – wie geht es weiter?
Ist der Schimmelbefall schwerwiegend, hilft nur professionelle Hilfe und eine Sanierung der Immobilie. Doch auch hier sollten Sie auf Erfahrung und Qualität achten, um den Schimmelpilz langfristig aus dem Haus oder aus der Wohnung zu entfernen.
Zu einer umfassenden Sanierung einer Immobilie mit Schimmelbefall gehört beispielsweise die Feinreinigung der Luft durch besondere Schutzmaßnahmen, sowie eine Begleitung und Unterstützung des Projektes durch Experten. (Baubiologie – bbgeiger.de)
